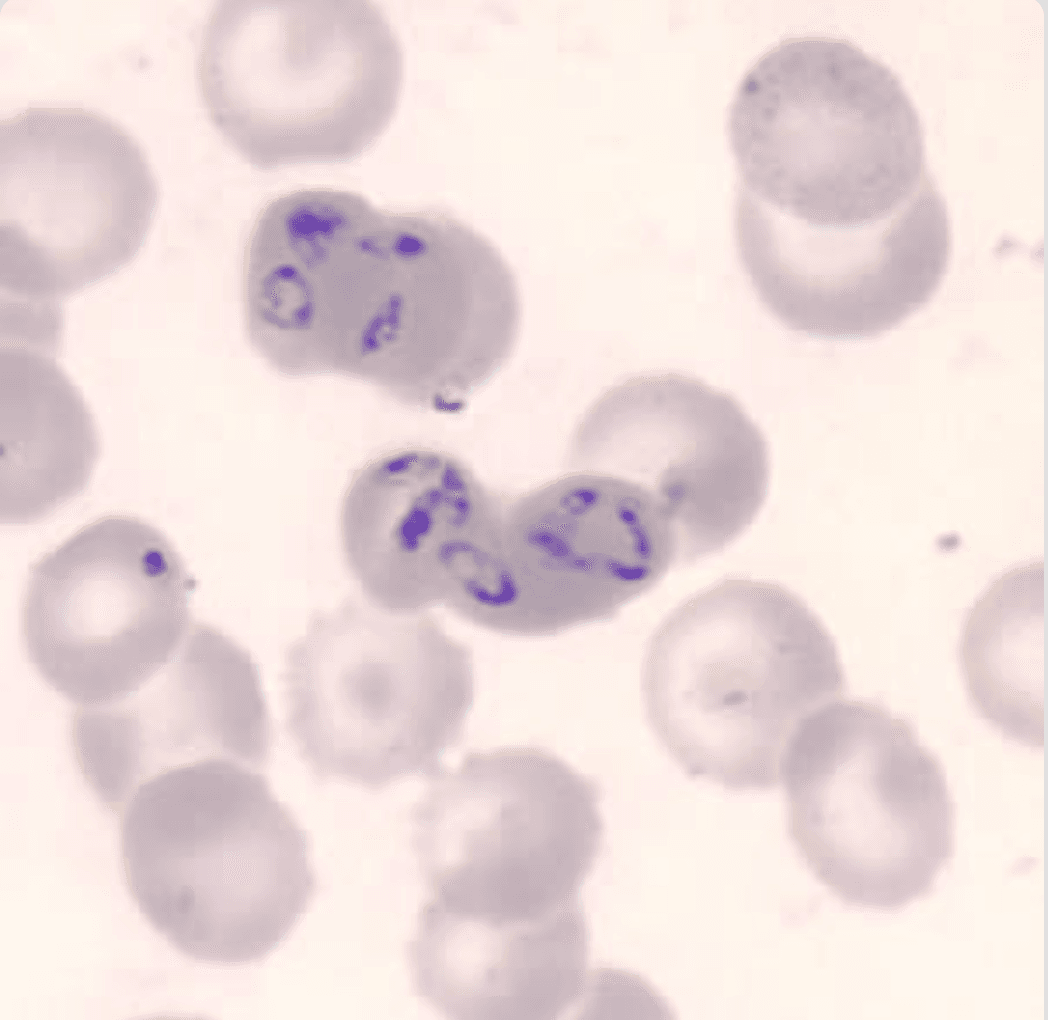
Peripheral blood smear showing small intraerythrocytic ring forms with multiple parasites per erythrocyte and extracellular ring forms consistent with Babesia microti

Two Continents, One Smear
Clinical Vignette
A 68-year-old man presents to the emergency department with one week of daily fevers, drenching night sweats, fatigue, and dark urine. He has no prior history of similar illness. His medical history is notable for a splenectomy performed 18 years ago following a motor vehicle accident. He takes no regular medications.
He returned 10 days ago from a 2-week safari in Kenya, where he spent time in rural areas including the Maasai Mara region. He did not take malaria chemoprophylaxis, as he had received conflicting advice and ultimately did not fill the prescription. Three weeks before his departure to Kenya, he had spent a long weekend camping and hiking on Nantucket Island with family.
On examination he is febrile to 39.1°C, blood pressure 108/72 mmHg, heart rate 112 bpm, and oxygen saturation 96% on room air. He appears ill and mildly jaundiced. There is no palpable spleen. The remainder of the examination is unremarkable.
Hemoglobin is 8.4 g/dL, platelet count 68,000/μL, and white blood cell count 5,200/μL. LDH is 740 U/L, total bilirubin 3.8 mg/dL (indirect 3.1 mg/dL), haptoglobin is undetectable, and reticulocyte count is elevated. Creatinine is 2.1 mg/dL. Direct antiglobulin test (DAT) is negative. Peripheral blood smear reveals small intraerythrocytic ring forms with multiple parasites per erythrocyte, occasional extracellular ring forms, and a parasitemia of approximately 8%.
Peripheral blood smear: intraerythrocytic ring forms
Question 1
Which of the following is the most likely diagnosis?
Select one option to submit your answer and view live poll results.
Question 2
The diagnosis of Babesia microti is confirmed by PCR. Which of the following is the most appropriate treatment?
Select one option to submit your answer and view live poll results.
References
Sanchez E, Vannier E, Wormser GP, Hu LT. Diagnosis, treatment, and prevention of Lyme disease, human granulocytic anaplasmosis, and babesiosis: a review. JAMA. 2016;315(16):1767-1777.
Krause PJ, Auwaerter PG, Bannuru RR, et al. Clinical Practice Guidelines by the Infectious Diseases Society of America (IDSA): 2020 Guideline on Diagnosis and Management of Babesiosis. Clinical Infectious Diseases. 2021;73(1):e1-e42.
Krause PJ, Auwaerter PG, Bannuru RR, et al. Correction to: Clinical Practice Guidelines by the Infectious Diseases Society of America: 2020 Guideline on Diagnosis and Management of Babesiosis. Clinical Infectious Diseases. 2021;73(1):172.
Vannier EG, Diuk-Wasser MA, Ben Mamoun C, Krause PJ. Babesiosis. Infectious Disease Clinics of North America. 2015;29(2):357-370.